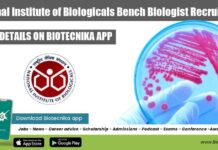
National Institute of Biologicals Bench Biologist Recruitment NIB Bench Biologist Job

Govt RGCB GenomeIndia Project Job With Rs. 70,000 pm Pay For Biotech & Life...
RGCB Project Job - Biotech & Life Sciences Apply Online
RGCB Project Job - Biotech & Life Sciences Apply Online. RGCB, Thiruvananthapuram is hiring MSc...
NIAB Project Associate Recruitment, Online Application Process
NIAB Associate Job For Life Sciences, Apply Online
NIAB Associate Job For Life Sciences, Apply Online. National Institute of Animal Biotechnology (NIAB) is hiring for...
CSIR-IMTECH Life Sciences Project Associate Recruitment, Online Application Process
IMTECH MTech & MSc Jobs, Applications Invited Online
IMTECH MTech & MSc Jobs, Applications Invited Online. Project Associate Recruitment. MSc Life Sciences/ Microbiology/ Biotechnology/Biochemistry &...
Biotecnika Times Newsletter 14.09.2021 – DRDO-DIPAS Life Science Recruitment, Govt Silk
Biotecnika Times - DRDO-DIPAS Life Science Recruitment, Govt Silk
DRDO-DIPAS Life Sciences Research Associate Recruitment - Download Biotecnika App to Apply
DRDO-DIPAS Life Sciences Research Associate...
15 Points Action Plan In Absence of CSIR NET This Year
CSIR NET Action Plan - What to do in absence of CSIR NET Exam
15 points: What should be your action plan in absence of...
Govt Silk Board, Seribiotech Research Lab BIRAC Funded Project Recruitment
Govt Silk Board, Seribiotech Research Lab BIRAC Funded Project Recruitment
Govt Silk Board, Seribiotech Research Lab BIRAC Funded Project Recruitment. MSc Biotechnology/Biochemistry/Microbiology junior and senior...
Intranasal Mucosal Vaccine For COVID-19 Project Recruitment at ICMR-NIRRH
ICMR-NIRRH Project Jobs - Life & Biological Sciences Post
ICMR-NIRRH Project Jobs - Life & Biological Sciences Post. NIRRH recruitment for MSc Biological and Life...
Sanofi Life Sciences Analyst Recruitment, Online Application Process
Sanofi Life Sciences Analyst Recruitment, Online Application Process
Sanofi Life Sciences Analyst Recruitment, Online Application Process. Sanofi is hiring candidates with relevant experience for an...
IISER Kolkata PhD Biological Sciences Research Associate Job
IISER Kolkata PhD Biological Sciences Research Associate Job
IISER Kolkata PhD Biological Sciences Research Associate Job. PhD Biological Sciences applicants are eligible to apply for...
ICGEB MSc Biotech & Life Sciences Research Fellow Recruitment
ICGEB Vacancy Available For MSc Biotech & Life Sciences
ICGEB Vacancy Available For MSc Biotech & Life Sciences. MSc Biotechnology & Life Sciences candidates are...
ILBS CCRAS Research Fellow Recruitment, Applications Invited
ILBS SRF Jobs - Applications Invited From MSc Life Sciences
ILBS SRF Jobs - Applications Invited From MSc Life Sciences. MSc & BSc candidates apply...
IISER Pune Biology, Biotech, Botany Research Associate Recruitment
IISER Pune Associate Job - PhD Biology, Botany & Biotech
IISER Pune Associate Job - PhD Biology, Botany & Biotech. IISER Pune is hiring for...
DRDO-DIPAS Life Sciences Research Associate Recruitment
DRDO-DIPAS Life Sciences Research Associate Recruitment
DRDO-DIPAS Life Sciences Research Associate Recruitment. DRDO- Defence Institute of Physiology and Allied Sciences (DIPAS) recruiting for research associate...
Govt NIRF-MHRD Ranking 2021 – Top 25 College List in India
Top 25 Colleges List in India - Govt NIRF-MHRD Ranking 2021
List of Top 25 Colleges 2021 has been released by NIRF - MHRD Govt...
Top 25 Universities In India As Per Govt NIRF-MHRD Ranking 2021
Top 25 Indian Universities As Per Govt NIRF-MHRD Ranking 2021
List of Top 25 Indian Universities 2021 has been released by NIRF - MHRD Govt...